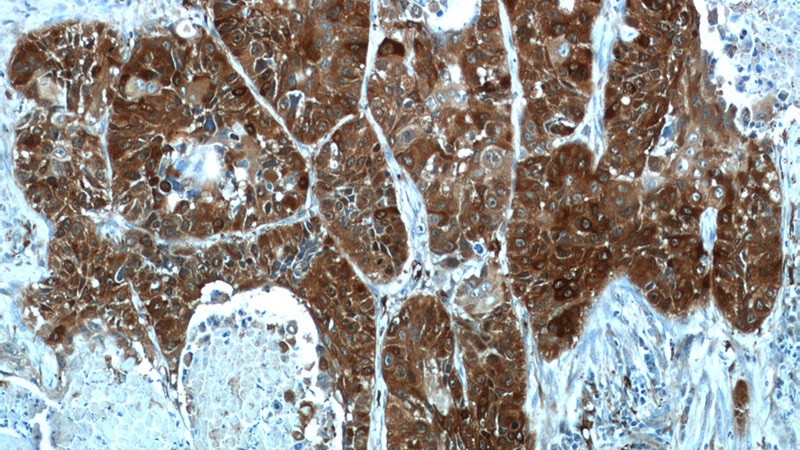
Immunohistochemistry of paraffin-embedded human lung cancer tissue slide using Catalog No:115602(SRX1 Antibody) at dilution of 1:50 (under 10x lens)
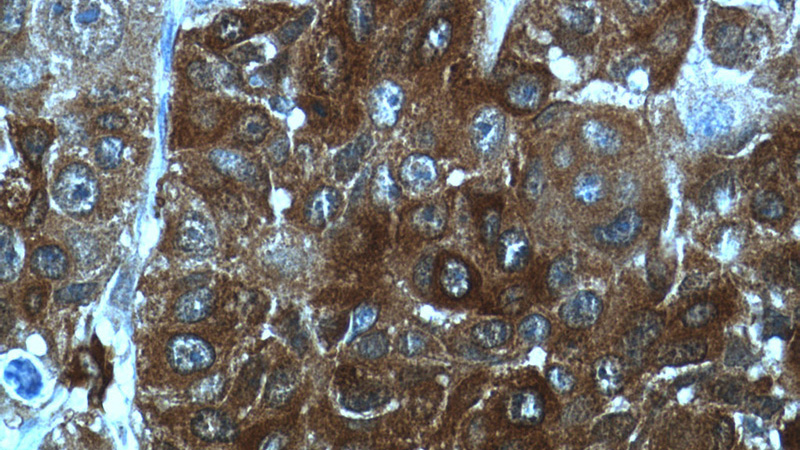
Immunohistochemistry of paraffin-embedded human lung cancer tissue slide using Catalog No:115602(SRX1 Antibody) at dilution of 1:50 (under 40x lens)

-
Product Name
SRX1 antibody
- Documents
-
Description
SRX1 Rabbit Polyclonal antibody. Positive WB detected in A549 cells, mouse liver tissue, Transfected HEK-293 cells. Positive IP detected in A549 cells. Positive IHC detected in human lung cancer tissue, human breast cancer tissue, human kidney tissue. Observed molecular weight by Western-blot: 14 kDa
-
Tested applications
ELISA, IP, IHC, WB
-
Species reactivity
Human, Mouse; other species not tested.
-
Alternative names
C20orf139 antibody; dJ850E9.2 antibody; SRX antibody; SRX1 antibody; SRXN1 antibody; Sulfiredoxin 1 antibody; YKL086W antibody
- Immunogen
-
Isotype
Rabbit IgG
-
Preparation
This antibody was obtained by immunization of SRX1 recombinant protein (Accession Number: NM_080725). Purification method: Antigen affinity purified.
-
Clonality
Polyclonal
-
Formulation
PBS with 0.02% sodium azide and 50% glycerol pH 7.3.
-
Storage instructions
Store at -20℃. DO NOT ALIQUOT
-
Applications
Recommended Dilution:
WB: 1:200-1:1000
IP: 1:200-1:1000
IHC: 1:20-1:200
-
Validations

A549 cells were subjected to SDS PAGE followed by western blot with Catalog No:115602(SRX1 antibody) at dilution of 1:400

IP Result of anti-SRX1 (IP:Catalog No:115602, 3ug; Detection:Catalog No:115602 1:400) with A549 cells lysate 3300ug.
Immunohistochemistry of paraffin-embedded human lung cancer tissue slide using Catalog No:115602(SRX1 Antibody) at dilution of 1:50 (under 10x lens)
Immunohistochemistry of paraffin-embedded human lung cancer tissue slide using Catalog No:115602(SRX1 Antibody) at dilution of 1:50 (under 40x lens)
-
Background
SRXN1 represents sulfiredoxin 1 homolog (S. cerevisiae)
-
References
- Wei Q, Jiang H, Baker A. Loss of sulfiredoxin renders mice resistant to azoxymethane/dextran sulfate sodium-induced colon carcinogenesis. Carcinogenesis. 34(6):1403-10. 2013.
- Soini Y, Eskelinen M, Juvonen P. Nuclear Nrf2 expression is related to a poor survival in pancreatic adenocarcinoma. Pathology, research and practice. 210(1):35-9. 2014.
- Wu L, Jiang H, Chawsheen HA. Tumor promoter-induced sulfiredoxin is required for mouse skin tumorigenesis. Carcinogenesis. 35(5):1177-84. 2014.
- Hintsala HR, Soini Y, Haapasaari KM, Karihtala P. Dysregulation of redox-state-regulating enzymes in melanocytic skin tumours and the surrounding microenvironment. Histopathology. 67(3):348-57. 2015.
- Yu S, Wang X, Lei S. Sulfiredoxin-1 protects primary cultured astrocytes from ischemia-induced damage. Neurochemistry international. 82:19-27. 2015.
- Mazur W, Lindholm P, Vuorinen K, Myllärniemi M, Salmenkivi K, Kinnula VL. Cell-specific elevation of NRF2 and sulfiredoxin-1 as markers of oxidative stress in the lungs of idiopathic pulmonary fibrosis and non-specific interstitial pneumonia. APMIS : acta pathologica, microbiologica, et immunologica Scandinavica. 118(9):703-12. 2010.
- Merikallio H, Pääkkö P, Kinnula VL, Harju T, Soini Y. Nuclear factor erythroid-derived 2-like 2 (Nrf2) and DJ1 are prognostic factors in lung cancer. Human pathology. 43(4):577-84. 2012.
- Hartikainen JM, Tengström M, Kosma VM, Kinnula VL, Mannermaa A, Soini Y. Genetic polymorphisms and protein expression of NRF2 and Sulfiredoxin predict survival outcomes in breast cancer. Cancer research. 72(21):5537-46. 2012.
Related Products / Services
Please note: All products are "FOR RESEARCH USE ONLY AND ARE NOT INTENDED FOR DIAGNOSTIC OR THERAPEUTIC USE"
